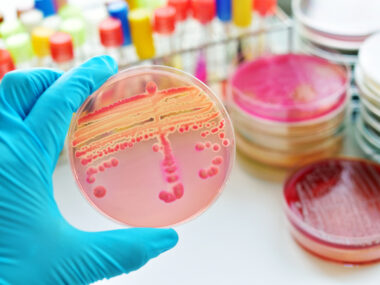

As part of the annual “March on the Hill” event in Washington, D.C., sponsored by the Cystic Fibrosis Foundation, Texas volunteers joined other advocates from across the U.S. to present Rep. Lloyd Doggett with the Legislative Champion Award for his efforts on behalf of the cystic fibrosis (CF) community. Congressman Doggett,…
 Fact-checked by
Fact-checked by